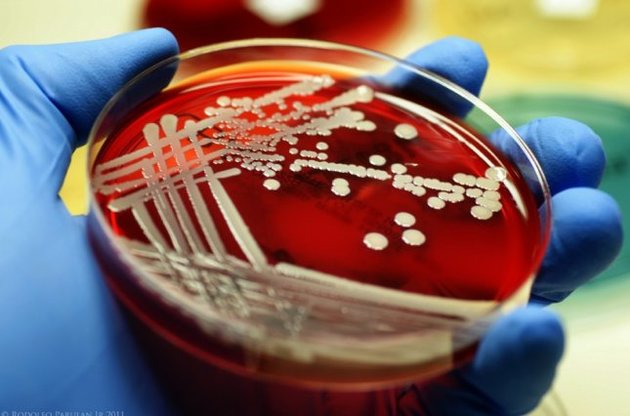
Золотистый стафилококк способен выпускать "ложные цели" для антибиотиков

Ученые из Имперского колледжа Лондона заявили о том, что золотистый стафилококк может выбрасывать "ложные цели", которые инактивируют антибиотики. Выводы ученых были опубликованы в Nature Microbiology.
Золотистый стафилококк – вид бактерий, который может вызывать широкий спектр заболеваний. Для борьбы с бактерией применяются антибиотики пенициллинового ряда (метициллин, оксациллин), а также даптомицин из группы циклических липопептидов. S. aureus может быть устойчивым ко всем этим соединениям.
В ходе нового исследования ученые проанализировали действие антибиотиков на различные штаммы бактерий. Результаты показали, что антибиотик значительно хуже действует на больничные штаммы S. aureus, для которых характерно нарушение работы системы Agr-вирлентности. Эта система позволяет некоторым бактериям координировать коллективную деятельность посредством химической стимуляции.
Дальнейшие наблюдения показали, что инактивация даптомицина связана с тем, что бактерии выделяют мицеллы фосфатидилглицерина (ФГ). Такой механизм характерен для всех штаммов возбудителя, однако эффективное связывание происходит только при дефекте системы Agr. В отсутствие дефекта фенол-растворимые модулины (ФРМ) предотвращают контакт ФГ с препаратом.
При этом дополнительная обработка оксациллином восстановила действие даптомицина. По словам авторов, в дозах, меньше терапевтических, первый снизил уровень ФГ, что позволило даптомицину беспрепятственно встроится в мембрану бактерий и повысить ее проницаемость. У природных штаммов S. aureus эффект на наблюдался: их ФРМ самостоятельно нейтрализовали выделение ФГ.
Ранее сообщалось о том, что бактерии приобрели устойчивость к антибиотикам "последней надежды". Это означает, что в скором времени возможно появление бактерий, стойких ко всем известным типам лекарств, и такие гены стойкости уже замечены у бактерий, которые поражают людей.